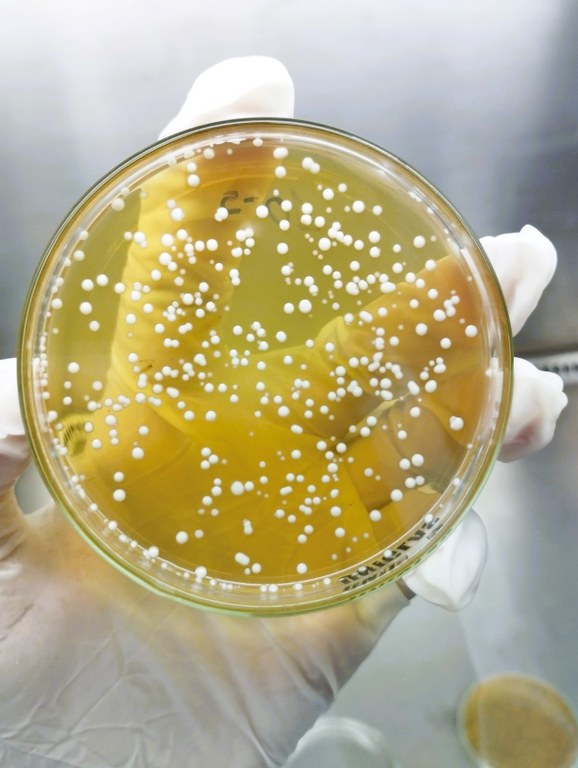

Confira a quinta edição do Diário COP30, produção do Laboratório Experimental de Jornalismo (Laborejo) da Universidade Federal do Maranhão (UFMA)
Ouça!
🌎 | Instagram | CANAL WHATSAPP | X | Spotify | Spotify Playlists |
Deezer | Amazon Music | Apple Podcasts
São Luís – MA
2025

Comentário de Paulo Pellegrini
Ouça!
🌎 | Instagram | CANAL WHATSAPP | X | Spotify | Spotify Playlists |
Deezer | Amazon Music | Apple Podcasts
São Luís – MA
2025

A Fundação Sousândrade de Apoio ao Desenvolvimento da Universidade Federal do Maranhão (UFMA) reforça no Mês da Consciência Negra, seu compromisso com ações estruturadas de combate ao racismo e de promoção da equidade.
📱Siga o Canal da Universidade FM no WhatsApp👆🏼
Nesse período de reflexão e aprendizado, a instituição destaca a importância de iniciativas que ampliem o debate público, fortaleçam a inclusão e contribuam para a construção de ambientes mais justos, onde todas as pessoas tenham suas identidades reconhecidas e respeitadas. Tais iniciativas encontram aporte no Primeiro Encontro Maranhense sobre Governança Antidiscriminatória e Antiassédio nas Organizações.
A ação afirmativa foi desenvolvida em parceria com o Instituto Enegrecer, na sexta-feira, 14 de novembro, em espaço localizado na Avenida Jerônimo de Albuquerque, no bairro Cohafuma. O evento constituiu-se em um importante momento de diálogo sobre práticas e políticas de inclusão e respeito no ambiente organizacional.
A iniciativa reforça a relevância do desenvolvimento de programas, eventos e formações voltados à valorização da diversidade racial, reafirmando o papel da Fundação Sousândrade na transformação social. Iniciativas como essa, não apenas sensibilizam, mas também impulsionam mudanças concretas dentro e fora das organizações, reforçando que a luta antirracista é contínua e essencial para a construção de uma sociedade verdadeiramente democrática.
Contou com a participação de representantes da direção superior da Universidade Federal do Maranhão, como o vice-reitor Leonardo Soares e a pró-reitora de Extensão e Cultura, professora Zefinha Bentivi.

Presidente da FSADU-UFMA, Prof. Walter Nunes, observado pelo diretor de Diversidade, Inclusão e Ação Afirmativa da UFMA, Acildo Leite da Silva (Foto: Fabianne Matos)
O presidente da Fundação Sousândrade, professor doutor Walter Cezar Nunes, também participou do encontro e destacou a relevância da proposta.
“O tema em questão é muito atual, sensível e importante para a sociedade. A Fundação já trabalha nessa política de manter uma gestão antidiscriminatória e respeitosa, para que as pessoas possam se sentir à vontade trabalhando na instituição. E isso deve reverberar no entorno, pois a Fundação tem muito respeito a essas práticas e sempre estará comprometida em manter essa integridade, para que as pessoas possam trabalhar normalmente, sem problemas, pautadas na consciência de que o racismo e a discriminação não têm lugar aqui”, observou.
Os painéis do Primeiro Encontro Maranhense sobre Governança Antidiscriminatória e Antiassédio nas Organizações foram concebidos em perspectiva ampla, não restrita à realidade da Fundação Sousândrade, promotora da iniciativa. O encontro buscou envolver as pessoas convidadas e dialogar com instituições públicas, organizações privadas e do terceiro setor, criando um espaço coletivo de reflexão e troca de práticas. Dessa forma, o evento se propôs a fortalecer a governança inclusiva como princípio transversal e indispensável para ambientes institucionais mais éticos, seguros e comprometidos com a dignidade de todas as pessoas.
Tais observações são intrínsecas quando se pensa em governança antidiscriminatória e antiassédio nas organizações, que consistem no estabelecimento de políticas, práticas e mecanismos de monitoramento que previnam desigualdades e comportamentos abusivos, promovendo ambientes seguros, inclusivos e responsáveis. Assim, ao integrar diretrizes claras, canais confiáveis de denúncia e processos transparentes de apuração, essas abordagens fortalecem a cultura ética, reduzem riscos legais e reforçam o compromisso institucional com o respeito e a dignidade de todas as pessoas.
Ação afirmativa
As colocações foram reforçadas durante o encontro pela diretora executiva do Instituto Enegrecer, Manoela Alves — conhecida como Manu —, mulher negra, advogada, professora e palestrante. Como pesquisadora, tem atuação destacada nas interseções entre gênero, raça e tecnologia. É Mestre em Direito pela Universidade Católica de Pernambuco e Especialista em Direito Público e Didática do Ensino Superior. Na docência, atua como professora de Direito Constitucional em diferentes instituições de ensino superior, com trajetória consolidada na temática dos direitos humanos, especialmente nas pautas de gênero, raça e população LGBTQIA+.
Para Manu, a diversidade não é apenas um valor, mas uma estratégia inteligente para organizações que desejam relevância, sustentabilidade e propósito, reflexões aprofundadas na palestra ministrada por ela durante o encontro.
“Acredito que toda organização hoje precisa se preocupar com a pauta do combate ao assédio. Temos uma tendência ao aumento de práticas de assédio, sobretudo diante do avanço tecnológico e de um mundo em que temos visto grandes guerras de ideias e pessoas mais à vontade para proferir pensamentos discriminatórios. Nessa perspectiva, manter esse tipo de debate em todas as organizações é garantir responsabilidade social na construção de uma sociedade mais justa, com equidade e contra todo e qualquer tipo de opressão dentro de um país tão desigual como o Brasil”, destacou a especialista ao comentar a pertinência da iniciativa da Fundação.
Para além de iniciativas como o Primeiro Encontro Maranhense sobre Governança Antidiscriminatória e Antiassédio nas Organizações, a diretora executiva do Instituto Enegrecer observou que as instituições podem avançar ainda mais.
“O evento é uma ação afirmativa implementada pela Fundação Sousândrade que contribui sobretudo por estarmos em novembro, o Mês da Consciência Negra. Mas, para além disso, é preciso trabalhar no dia a dia o combate ao racismo, à homofobia, à misoginia e ao capacitismo. É importante olhar para as pessoas que fazem parte da organização e perceber se elas refletem a pluralidade da sociedade. É essencial verificar se essas pessoas estão sendo cuidadas e se há protocolos que garantam um tratamento respeitoso. Governança é garantir que, não apenas nesta gestão, mas nas próximas, o compromisso com a valorização da diversidade permaneça — e assim combatemos o racismo e as demais opressões ao longo dos 365 dias do ano”.
A iniciativa da Fundação Sousândrade, em parceria com o Instituto Enegrecer, ao promover o Primeiro Encontro Maranhense sobre Governança Antidiscriminatória e Antiassédio nas Organizações, reforça a crescente relevância da discussão sobre o papel das instituições no combate ao racismo e às discriminações que permeiam o ambiente social. Reafirma, ainda, seu papel enquanto entidade atenta aos interesses e às demandas da sociedade.

A mesa do evento contou diversos representantes institucionais parceiros da FSADU (Foto: Fabianne Matos)
Em tempo
Novembro foi escolhido como o Mês da Consciência Negra porque marca o dia 20, data da morte de Zumbi dos Palmares, líder do Quilombo dos Palmares e símbolo da resistência negra contra a escravidão no Brasil. A escolha reforça a importância de reconhecer a luta histórica do povo negro, valorizar sua contribuição para a formação do país e promover reflexões sobre racismo, igualdade e direitos ao longo de todo o mês.
(Borges Júnior)



PROCLAMAÇÃO DA REPÚBLICA:
- Comércio de São Luís pode funcionar durante o feriado
📱Siga o Canal da Universidade FM no WhatsApp👆🏼
CASO AGILITY CASH:
- Defensoria Pública ingressa com ação civil contra empresa por golpe contra aposentados
ENSINO MÉDIO:
- Colégio Universitário da UFMA abre inscrições para 2026
DIA MUNDIAL EM MEMÓRIA DAS VÍTIMAS DE ACIDENTES DE TRÂNSITO:
- Instituto SOS Vida Pela Paz no Trânsito desenvolve ação neste domingo
DIÁRIO COP30:
- Lideranças e pesquisadores afirmam que transição energética só será justa se incluir povos e comunidades afetados
ESPORTE:
- Arthur Elias convoca Mariza e Ary Borges para amistosos contra a Noruega e Portugal
- Desembargador suspende pedido da CBF de anulação do afastamento de dirigentes da FMF
- PS City e Os Canos se enfrentam na final da Copa Verão
PAULO PELLEGRINI:
- A duas rodadas do fim, Série B não tem nenhum time com acesso garantido
ROTEIRO CULTURAL:
- As melhores dicas de lazer para o seu fim de semana
Confira!
🌎 | Instagram | CANAL WHATSAPP | X | Spotify | Spotify Playlists |
Deezer | Amazon Music | Apple Podcasts
São Luís – MA
2025

- UFMA oferece atendimentos psicológicos gratuitos voltados para adultos e crianças até 11 anos de idade
- UFMA realiza campanha "Papai Noel dos Correios"
- Casa da Mulher Brasileira promove IX Corrida de Combate ao Feminicídio
Atitude Positiva: "Natal Que Acolhe Todo Dia" (Casa Acolher)
📱Siga o Canal da Universidade FM no WhatsApp👆🏼
Ouça!
🌎 | Instagram | CANAL WHATSAPP | X | Spotify | Spotify Playlists |
Deezer | Amazon Music | Apple Podcasts
São Luís – MA
2025
As infecções de pele causadas por bactérias resistentes a antibióticos têm se tornado um dos grandes desafios das ciências da saúde. O avanço da resistência microbiana - provocado principalmente pelo uso indiscriminado de medicamentos - tem incentivado a busca por soluções terapêuticas mais seguras e sustentáveis.
📱Siga o Canal da Universidade FM no WhatsApp👆🏼
Nesse cenário, a acadêmica de Biomedicina da Universidade Ceuma, Layse Ribeiro de Sousa Carvalho, investigou uma alternativa promissora que vem de uma fonte tipicamente nordestina: o leite fermentado da castanha de caju.
Layse pesquisou micro-organismos probióticos presentes nesse alimento e avaliou como eles podem atuar no combate a infecções cutâneas e no processo de cicatrização.
De acordo com a pesquisadora, a escolha da matriz vegetal não foi por acaso.
“O leite fermentado da castanha de caju foi escolhido justamente por ser uma fonte vegetal, e um recurso abundante no Nordeste, embora ainda pouco explorado. Com o avanço da resistência microbiana causada pelo uso indiscriminado de antibióticos, sentimos a necessidade de desenvolver novas abordagens terapêuticas utilizando antimicrobianos naturais”, explica.

Colônias isoladas do leite fermentado de castanha de caju
A pesquisadora isolou duas bactérias do tipo lactobacilos presentes no leite fermentado.
Os micro-organismos passaram por testes de tolerância a acidez, sais biliares, cloreto de sódio e radiação ultravioleta, condições que simulam, tanto o trato gastrointestinal, quanto ambientes semelhantes aos de uma pele lesionada.
Os resultados demonstraram que os isolados apresentam alta resistência e permanecem viáveis mesmo em situações adversas.
No campo da saúde da pele, estudos recentes já indicam que bactérias ácido-láticas podem auxiliar na regeneração de feridas e na proteção contra agentes patogênicos.
Layse destaca que “esses micro-organismos mostram potencial na cicatrização de feridas, no combate a processos inflamatórios e na resistência contra infecções causadas por patógenos multirresistentes”.
Ela ainda reforça que a intenção da pesquisa é avançar para formulações tópicas - que são aplicadas diretamente na pele - que usam essas cepas probióticas no tratamento e prevenção de infecções.

Os resultados apontam que as bactérias isoladas são seguras, apresentam bom desempenho e podem ser aplicadas futuramente em produtos farmacêuticos, cosméticos e terapêuticos.
No entanto, a pesquisadora lembra que ainda são necessários estudos clínicos antes que qualquer formulação chegue ao uso cotidiano.
Layse teve orientação do professor doutor Luis Cláudio Nascimento da Silva, do Programa de Pós-Graduação em Biologia Microbiana, da Universidade Ceuma, com apoio da Fundação de Amparo à Pesquisa e ao Desenvolvimento Científico e Tecnológico do Maranhão (Fapema).
(Bruno Goulart)
Ouça!
🌎 | Instagram | CANAL WHATSAPP | X | Spotify | Spotify Playlists |
Deezer | Amazon Music | Apple Podcasts
São Luís – MA
2025